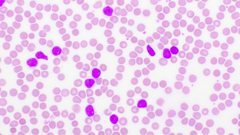

Gary Philipson Clips
-
![]()
Tim Hortons arrives at Teesside Park
Duration: 08:23
-
![]()
Teesside Uni Senior Lecturer to represent Team GB
Duration: 07:21
-
![]()
Lucy completes her trek for the Great North Air Ambulance
Duration: 06:01
-
![]()
Do you still "invest in green" despite rising costs?
Duration: 06:28
-
![]()
Halo Project "continues" jubilee celebrations
Duration: 07:04
-
![]()
The UK鈥檚 only Microcar specialist is in Billingham!
Duration: 08:21
-
![]()
Hundreds attend WW2 veteran's funeral after appeal.
Duration: 07:09
-
![]()
Louise Baldock is a local DNA detection expect
Duration: 11:18
-
![]()
Ash shares his story of living with Pancreatic cancer.
Duration: 13:34
-
![]()
A Way 蜜芽传媒 - The fight for a place
Duration: 10:20
-
![]()
"Pigeon Men" documentary launched
Duration: 14:02
-
![]()
Local celebrations for Africa Day
Duration: 05:46
-
![]()
A musical inspiration to others during lockdown
Duration: 04:28
-
![]()
Wing Walk planned for James Cook
Duration: 09:39
-
![]()
What is the Perimenopause?
Duration: 13:49
-
![]()
22-year-old Boro girl in desperate need of help
Duration: 18:16
-
![]()
Frontline Ukraine Charity announce festival
Duration: 09:49
-
![]()
Raising awareness of bone marrow donation
Duration: 20:57
-
![]()
Are you ready to pull the plug on petrol ?.
Duration: 04:22
-
![]()
Early Permanence aims to get children settled sooner
Duration: 05:16
-
![]()
Redcar mums clever invention goes global!
Duration: 15:29
-
![]()
Emma Raducanu's US Open trophy comes to a school in Nunthorpe
Duration: 04:51